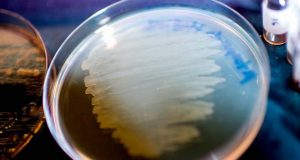

Mengungkap Gigitan Beracun Mamalia yang Selamat dari Hantaman Asteroid
Sekitar 66 juta tahun yang lalu, sebuah asteroid menabrak Bumi dan melenyapkan dinosaurus beserta tiga per empat kehidupan yang ada. Sisanya mungkin telah selamat...
Antibiotik Superbug Ditemukan dari Sejenis Cacing
Para ilmuwan terus berupaya mencari cara untuk memerangi superbug, yaitu kuman yang kebal terhadap efek antibiotik, dan ini tidaklah mudah, karena semakin hari semakin...
Bayi dalam Kandungan Lebih Dapat Melihat dari yang Diperkirakan
Jauh sebelum dapat melihat, bayi telah memiliki kemampuan dalam mendeteksi cahaya sejak dalam kandungan, menurut temuan terbaru para ilmuwan dari University of California, Berkeley.
Meskipun demikian,...
Blok Bangunan Kehidupan Ditemukan pada Meteorit oleh NASA
Sementara awal kehidupan diduga secara tunggal perlahan muncul pada sebuah genangan air di Bumi, namun sepertinya, prosesnya bisa dipercepat dengan kedatangan berbagai mereor yang...